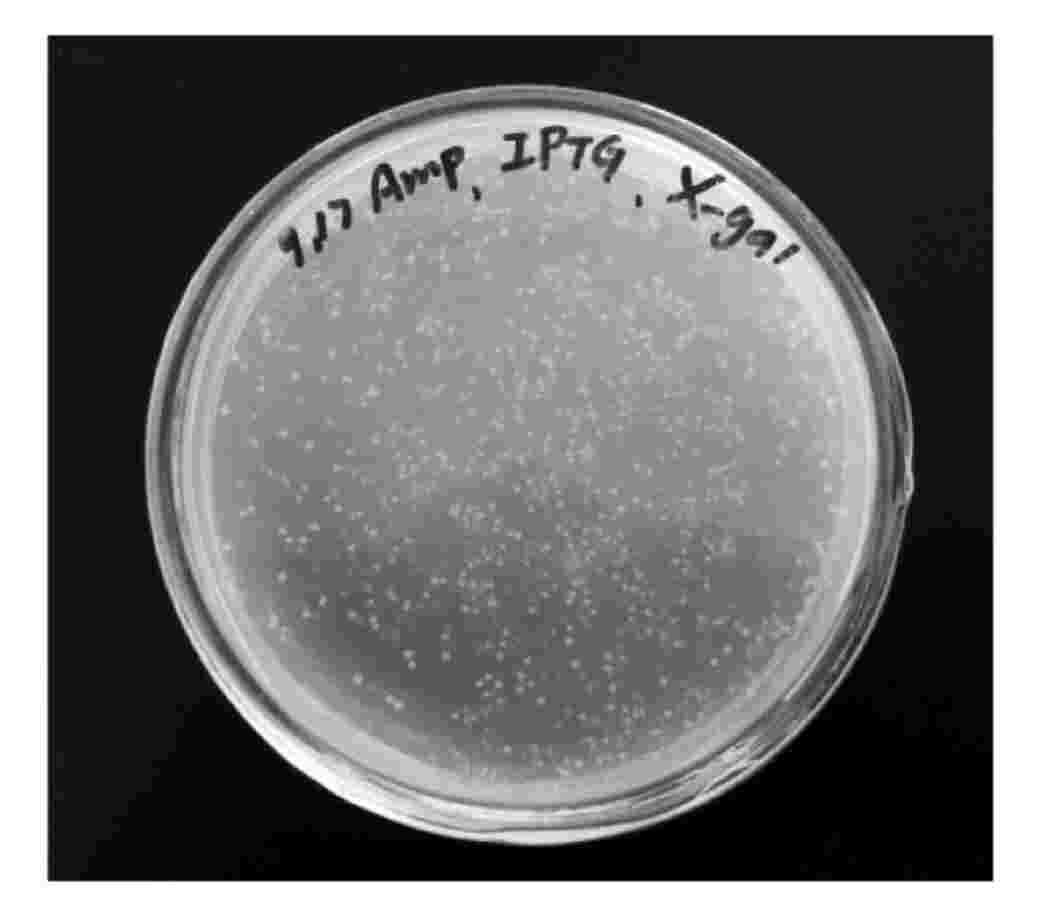

实验六 重组子的蓝白斑筛选
一、实验目的
1.从转化子中筛选出已插入目的基因的重组转化子。
2.学习蓝白斑筛选的原理。
3.学会计算转化效率。
二、实验原理
蓝白斑筛选是重组子筛选的一种方法,这种方法主要是基于α-互补现象而建立。现在使用的许多质粒载体(如pUC系列和它们的衍生载体)都带有一个大肠杆菌DNA的短片段,其中含有β-半乳糖苷酶(lacZ)N端144个氨基酸的编码信息及调控序列,在这个编码区中插入了一个多克隆位点,它并不破坏阅读框,这种类型的载体适用于可编码β-半乳糖苷酶C端部分的宿主细胞。因此,宿主和载体编码的片段都没有活性,但它们同时存在时,能够融为一体,形成具有酶活性的蛋白质。这样,lacZ基因上缺失操纵基因区段的突变体与带有完整的近操纵基因区段的质粒之间实现了互补,这种互补现象称为α-互补。由α-互补而产生的lac细菌菌落易于识别,因为它们在诱导剂IPTG的作用下,在生色底物X-gal存在的情况下形成蓝色菌落,然而外源DNA片段插入到质粒的多克隆位点后,几乎不可避免地导致产生无α-互补能力的N端片段。使得携带重组质粒的细菌形成白色菌落,这种重组子的筛选又称为蓝白斑筛选。这一简单的颜色实验大大简化了在这种构建质粒载体中鉴定重组子的工作,仅仅通过目测就可以轻而易举地筛选数千个菌落,并识别可能含有重组质粒的菌落,然后通过小量制备质粒DNA,进而用限制性内切酶酶切分析或其他方法就可以确定这些质粒的结构。
三、器材和试剂
超净工作台、三角推棒、酒精灯、移液器吸嘴、微量移液器、恒温培养箱
LB琼脂平板(氨苄抗性)、5%X-gal溶液、2%IPTG溶液、转化菌液、LB液体培养基
四、操作步骤
(一)蓝白斑筛选的基本操作
1.在含有Amp的预制90mm LB琼脂板中央滴加16μL 5%X-gal和70μL 2%IPTG的混合液。
2.用一个无菌的三角推棒拨散X-gal/IPTG混合液,使之均匀分散于培养皿整个表面,于37℃温育片刻直至全部液体吸收。
3.接种需要鉴定的细菌,100μL菌液(50 000个细胞/μL)铺板。
4.待接种液完全吸收后,颠倒培养皿于37℃培养箱倒置培养12~19h。
5.取出培养皿,4℃放置数小时(过夜),使蓝色在这一期间充分显色。
6.鉴定携带重组质粒的克隆(图3-4)。
图3-4 蓝白斑筛选的LB琼脂平板
(二)计算转化效率和阳性克隆的百分比
统计每个培养皿中的菌落数,按下列公式计算转化率:
1.转化体总数=菌落数×(转化反应原液总体积/涂板菌液体积)
2.转化率=转化体总数/加入质粒DNA的量(计算每微克的转化菌落数)
3.阳性克隆(%)=白色菌落数/(蓝色菌落数+白色菌落数)×100%
五、实验结果与分析
转化体总数=
转化率=
阳性克隆(%)=
六、参考文献
[1] 〔美〕奥斯伯,等.精编分子生物学实验指南.4版.马学军,等译校.北京:科学出版社,2005.
[2] 〔美〕J.萨姆布鲁克,等.分子克隆实验指南.3版.黄培堂,等译.北京:科学出版社,2008.





.jpg)
.jpg)
